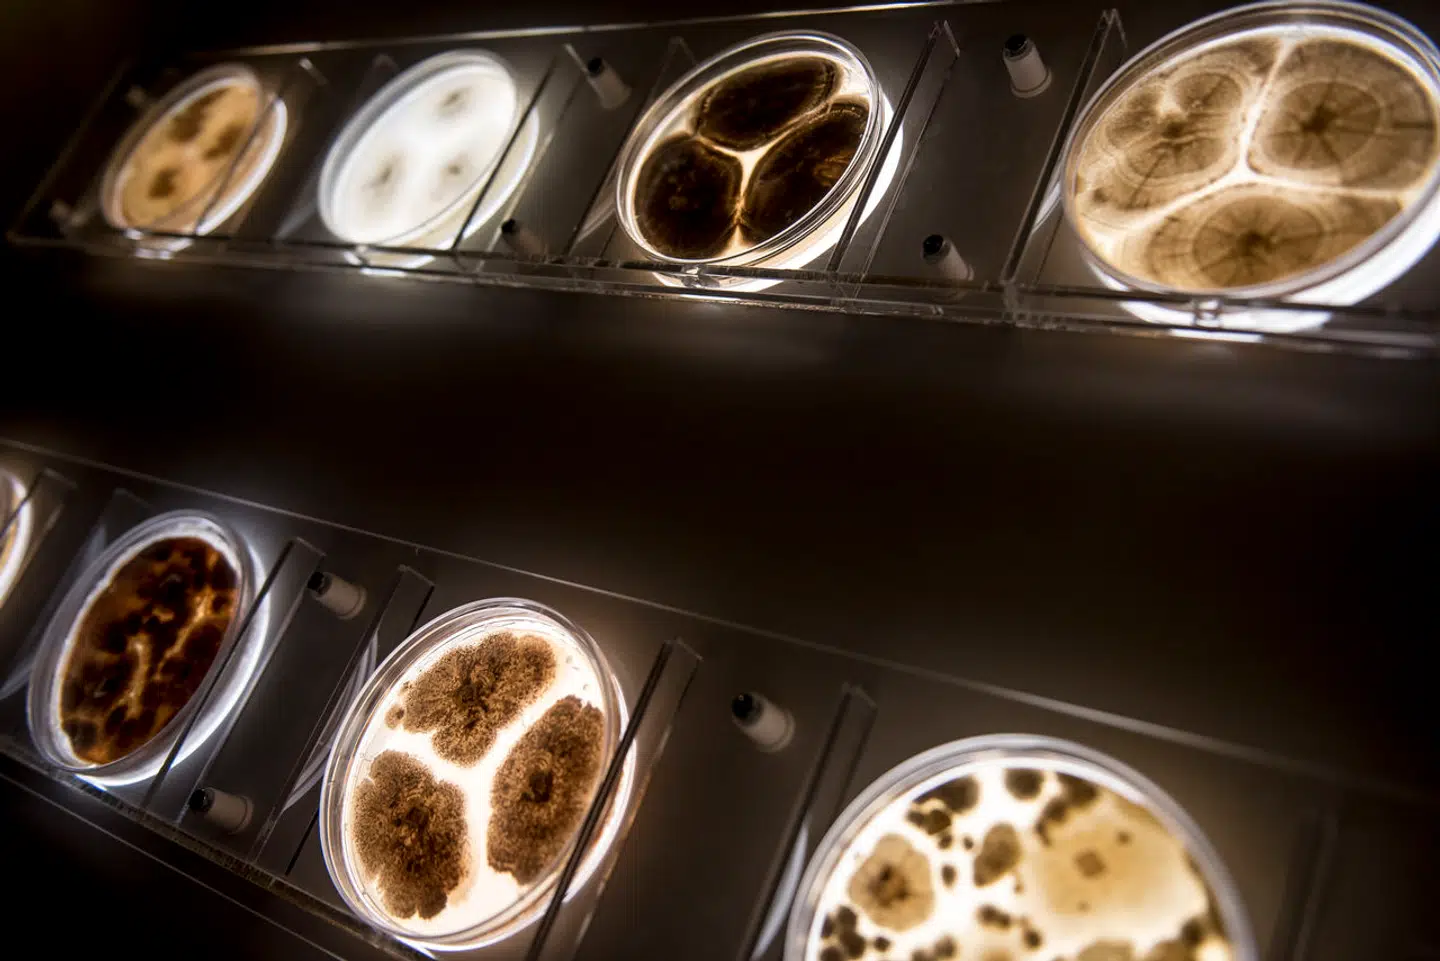

Sådan rammer fusion gamle investorer i Chr. Hansen og Novozymes

Gamle aktionærer i Chr. Hansen og Novozymes har nu fået en ny aktie i porteføljen - nemlig Novonesis.
Hvordan det er gået til er dog forskelligt, om man førhen havde aktier i den ene eller anden enzymproducent.
For kort tid siden blev en af de største virksomhedsfusioner i nylig dansk børshistorie gennemført, da de to enzymproducenter Chr. Hansen og Novozymes blev slået sammen i starten af 2023 under det nye navn Novonesis. De nye Novonesis-aktier havde første handelsdag den 31. januar.
Men hvad betyder det for dig som aktionær, hvis du før sammenlægningen havde aktier i Novozymes eller Chr. Hansen?
Hvis man før havde aktier i Novozymes, så vil du meget simpelt fortsat have de samme aktier bare under navnet Novonesis.
Hvis man derimod havde Chr. Hansen-aktier er det en smule mere indviklet. Her er der nemlig et ombytningsforhold, der lyder på 1,5326. Det vil sige, at hver Chr. Hansen-aktie svarer til 1,5326 Novonesis-aktie.
Det betyder også, at man kan kunne ende med at have fraktionerede aktier, altså dele af en aktie, i Novonesis. For eksempel hvis man havde 100 Chr. Hansen-aktier, vil man efter sammenlæningen have 153,26 Novonesis-aktier.
»I det tilfælde, du beskriver, vil aktionæren modtage kontanter for den resterende fraktionsdel, altså 26 pct. af kursen på en Novozymes-aktie,« oplyser Novonesis til Euroinvestor.
De tilføjer, at pengene blev udbetalt til aktionærerne den 2. februar.
Hvis du har Novonesis-aktier i din portefølje, kan du muligvis sta Novozymes har indkaldt til en ekstraordinær generalforsamling den 4. marts 2024, hvor det nye navn skal stemmes igennem.
Læs også: Nye beregninger: Det betyder omkostningerne for investeringer
Læs også: Sydbank anbefaler at sælge Mærsk: 'Kurs mod svageste resultat nogensinde'